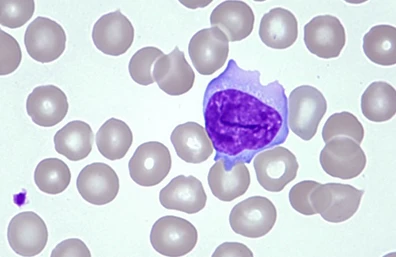

Se você está estudando hematologia ou já começou a rotina em laboratório, provavelmente já se deparou com a dificuldade de diferenciar células no esfregaço sanguíneo. Entre essas dúvidas, uma das mais importantes é entender a diferença entre linfócitos reativos e neoplásicos. Na prática, essa distinção pode impactar diretamente a interpretação de um hemograma e até levantar suspeitas clínicas relevantes.
Logo no início da formação, você aprende a reconhecer um linfócito típico, mas à medida que surgem variações morfológicas, o cenário fica mais desafiador. Saber como identificar linfócitos reativos, reconhecer as alterações morfológicas dos linfócitos e entender quando suspeitar de linfócitos neoplásicos são habilidades essenciais para qualquer estudante de biomedicina. Neste guia, vamos explorar de forma prática e objetiva como diferenciar essas células, especialmente como diferenciar linfócitos reativos de neoplásicos no microscópio, com foco em análise real de laboratório.
O que são Linfócitos?
Os linfócitos são células fundamentais do sistema imunológico, responsáveis pela defesa do organismo contra agentes infecciosos e células anormais. No esfregaço sanguíneo, o linfócito típico costuma apresentar tamanho pequeno a médio, núcleo arredondado com cromatina densa e um citoplasma escasso e levemente basofílico.
Na rotina laboratorial, reconhecer esse padrão é o primeiro passo para identificar desvios. Isso porque qualquer alteração significativa pode indicar desde uma resposta imunológica benigna até processos mais graves. As alterações morfológicas dos linfócitos são justamente o ponto de atenção, pois indicam que algo está acontecendo no organismo.
O que são Linfócitos Reativos?
Os linfócitos reativos são células que sofreram alterações em resposta a estímulos antigênicos, como infecções virais (ex: mononucleose). Eles não são malignos, mas apresentam mudanças importantes na morfologia, o que pode gerar dúvidas durante a análise microscópica.
As características morfológicas dos linfócitos reativos incluem aumento do tamanho celular, citoplasma abundante e mais basofílico, além de um núcleo que pode parecer menos condensado. Em alguns casos, o citoplasma pode “abraçar” hemácias ao redor, o que é um indicativo clássico.
Entender como identificar linfócitos reativos é essencial para evitar interpretações equivocadas. Muitos iniciantes confundem essas células com formas neoplásicas, principalmente pela aparência “atípica”. Por isso, observar o contexto clínico e a diversidade celular é fundamental.
O que são Linfócitos Neoplásicos?
Os linfócitos neoplásicos (clonais) são células originadas de uma proliferação descontrolada, geralmente associada a doenças como leucemias e linfomas. Diferente dos linfócitos reativos, essas células fazem parte de um processo maligno e costumam apresentar maior uniformidade morfológica.
Uma das principais características é justamente essa homogeneidade: ao observar o esfregaço, muitas células parecem “iguais”, o que levanta um sinal de alerta. Além disso, podem apresentar núcleo irregular, cromatina frouxa ou nucléolos evidentes.
Saber quando suspeitar de linfócitos neoplásicos é uma habilidade crítica. Nem sempre a morfologia isolada fecha diagnóstico, mas ela orienta a necessidade de exames complementares, como imunofenotipagem. No laboratório, essa suspeita inicial faz toda a diferença. A foto na imagem abaixo mostra linfócitos neoplásicos na leucemia linfocítica aguda.

Diferença entre Linfócitos Reativos e Neoplásicos
A diferença entre linfócitos reativos e neoplásicos está principalmente na origem, função e padrão morfológico. Enquanto os reativos surgem como resposta do sistema imune, os neoplásicos são resultado de uma proliferação clonal anormal.
Na prática, a diversidade é um dos principais critérios. Os linfócitos reativos costumam apresentar grande variação de tamanho e forma, enquanto os linfócitos neoplásicos (clonais) tendem a ser mais uniformes. Esse detalhe é extremamente útil para quem está aprendendo como diferenciar linfócitos reativos de neoplásicos no microscópio.
Outro ponto importante é o contexto clínico. Infecções virais geralmente estão associadas a linfócitos reativos, enquanto quadros persistentes ou inexplicados podem indicar algo mais sério. Por isso, a análise nunca deve ser isolada — sempre considere o conjunto de informações.

Imunologia de Janeway – Kenneth Murphy – 8° Edição – Editora Artmed

Imunologia Celular e Molecular – Abbas & Lichtman & Pillai – 10° Edição – Editora Guanabara Koogan
Características Morfológicas dos Linfócitos Reativos
As características morfológicas dos linfócitos reativos são marcadas pela variabilidade. Essas células podem ser maiores que o normal, com citoplasma abundante e bordas irregulares. A coloração também tende a ser mais intensa, refletindo maior atividade metabólica.
Outro ponto clássico é o núcleo, que pode apresentar cromatina menos condensada e formato levemente irregular. Em alguns casos, há presença de nucléolos discretos. Essas alterações morfológicas dos linfócitos são indicativas de ativação celular, não de malignidade.
Características Morfológicas dos Linfócitos Neoplásicos
Já os linfócitos neoplásicos (clonais) apresentam um padrão mais repetitivo. As células tendem a ter tamanho semelhante entre si, com menos variação morfológica. Esse aspecto homogêneo é um dos principais sinais de alerta.
As alterações morfológicas dos linfócitos nesse caso incluem núcleo irregular, cromatina frouxa ou em padrão aberto, e presença de nucléolos evidentes. Em algumas neoplasias, podem surgir características específicas, como projeções citoplasmáticas ou formatos nucleares atípicos.
Entender essas diferenças é essencial para saber quando suspeitar de linfócitos neoplásicos. Ao contrário dos reativos, aqui a uniformidade é o principal indicativo. Para o estudante, desenvolver esse olhar crítico no microscópio é um diferencial enorme na prática laboratorial.
Como diferenciar Linfócitos Reativos de Neoplásicos no microscópio
Saber como diferenciar linfócitos reativos de neoplásicos no microscópio é uma habilidade que vem com prática, mas alguns critérios ajudam muito no início. O primeiro deles é observar a variabilidade: diversidade sugere reatividade; uniformidade sugere clonabilidade.
Outro ponto importante é analisar o citoplasma e o núcleo em conjunto. Linfócitos reativos costumam ter citoplasma mais abundante e irregular, enquanto os neoplásicos podem apresentar alterações nucleares mais marcantes.
Referências Bibliográficas:
- ABBAS, A. K.; LICHTMAN, A. H. Cellular and molecular immunology. 9. ed. Philadelphia, Penns.: Saunders, 2005.
- PINHO, Mariana Pereira. Análise do repertório de linfócitos T em pacientes com câncer: desvendando a resposta imune antitumoral em humanos. [S.l.]: Universidade de São Paulo, 19 jul. 2019.
- Disponível em: <https://www.sidalc.net/search/Record/dig-unc-ar-11086-21733/Description>. Acesso em: 12 abr. 2026.




